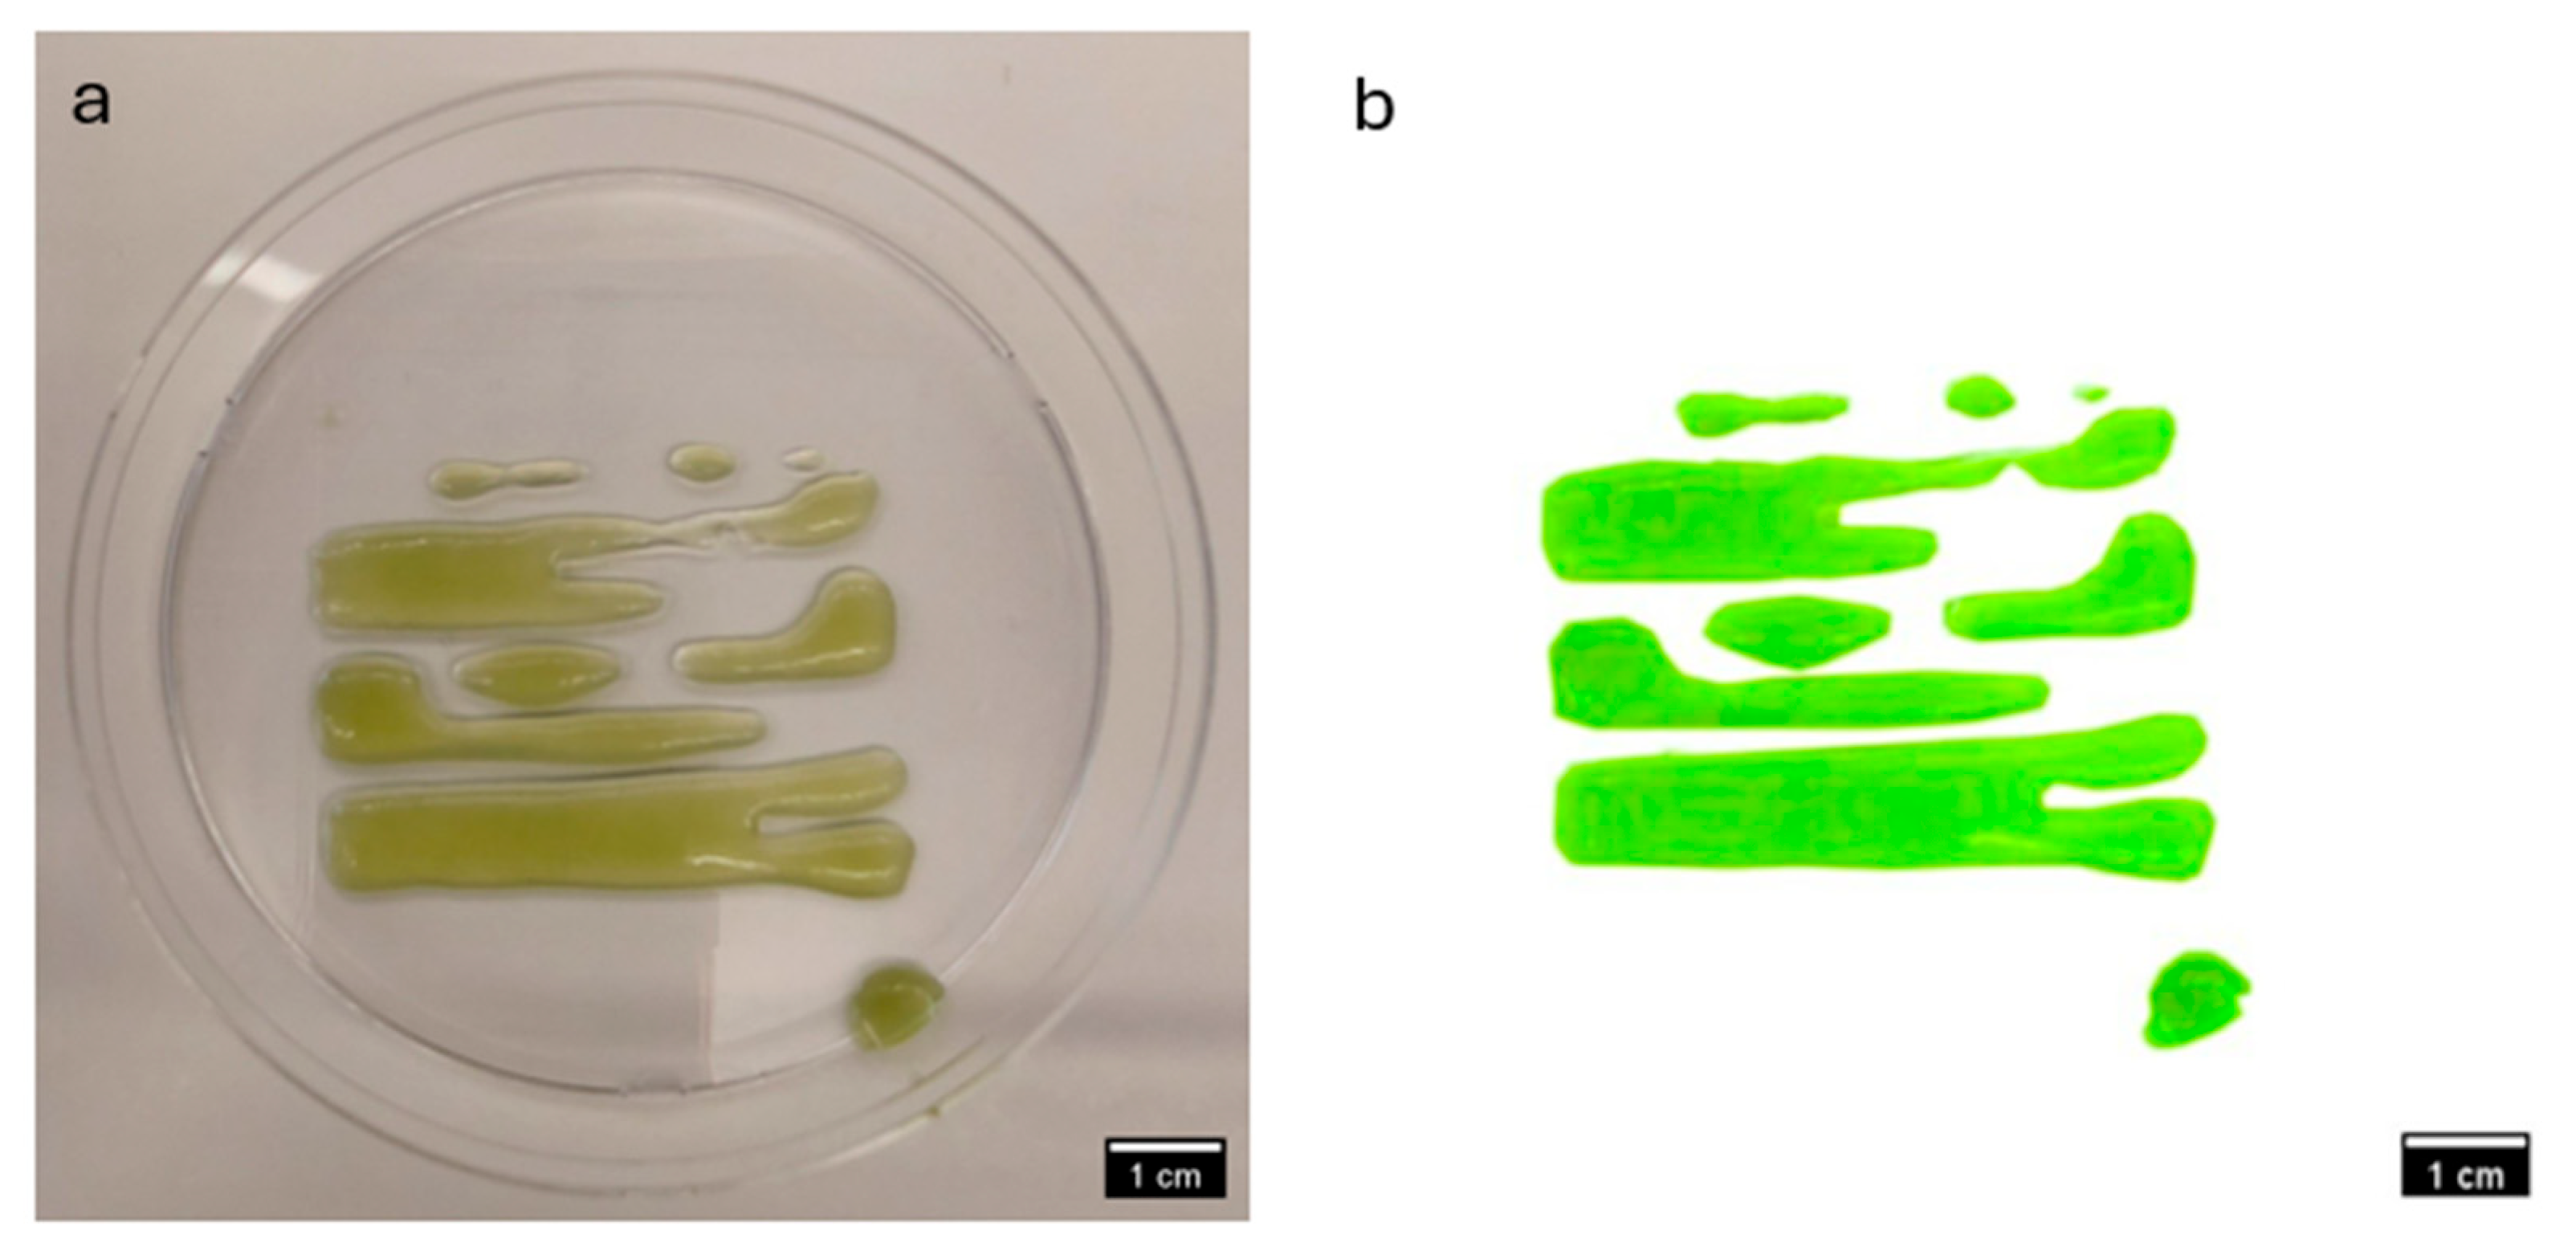
Materials 18 00753 g017

Evaluation of Custom Microalgae-Based Bioink Formulations for Optimized Green Bioprinting
Abstract
1. Introduction
2. Methodology
2.1. Scaffolding Materials
- Alginic Acid Sodium Salt (ALGINATE), derived from brown algae, obtained from SIGMA-ALDRICH, Co., St. Louis, MO, USA.
- Nanofibrillated Cellulose (NFC)—TEMPO, acquired from the University of Maine Process Development Center, Orono, ME, USA.
- Medium Viscosity CarboxyMethyl Cellulose (CMC), sourced from SIGMA-ALDRICH, Co., St. Louis, MO, USA.
2.2. Preparation of Substrates for Custom Bioinks
2.3. Cell Preparation and Culture
2.4. Preparation of Bioinks
2.5. Estimation of Cell Growth Rate in Substrates
2.6. Rheological Properties of Hybrid Substrates
2.7. Printability Test on Hydrogel and Bioink Formulations
3. Results and Discussion
3.1. Spectrophotometric and Rheological Analysis
3.2. Comparative Visual Assessment of Experimental Constructs
3.3. Insights into Bioink Formulation for Improved Bioprinting Performance
4. Conclusions
Author Contributions
Funding
Institutional Review Board Statement
Informed Consent Statement
Data Availability Statement
Conflicts of Interest
References
- Mandal, S.; Nagi, G.K.; Corcoran, A.A.; Agrawal, R.; Dubey, M.; Hunt, R.W. Algal polysaccharides for 3D printing: A review. Carbohydr. Polym. 2023, 300, 120267. [Google Scholar] [CrossRef] [PubMed]
- Sun, H.; Gong, Q.; Fan, Y.; Wang, Y.; Wang, J.; Zhu, C.; Mou, H.; Yang, S.; Liu, J. Unlocking 3D printing technology for microalgal production and application. Adv. Biotechnol. 2024, 2, 36. [Google Scholar] [CrossRef] [PubMed]
- Krujatz, F.; Dani, S.; Windisch, J.; Emmermacher, J.; Hahn, F.; Mosshammer, M.; Murthy, S.; Steingröwer, J.; Walther, T.; Kühl, M.; et al. Think outside the box: 3D bioprinting concepts for biotechnological applications—Recent developments and future perspectives. Biotechnol. Adv. 2022, 58, 107930. [Google Scholar] [CrossRef] [PubMed]
- Zhang, Y.S.; Yue, K.; Aleman, J.; Mollazadeh-Moghaddam, K.; Bakht, S.M.; Yang, J.; Jia, W.; Dell’Erba, V.; Assawes, P.; Shin, S.R.; et al. 3D Bioprinting for Tissue and Organ Fabrication. Ann. Biomed. Eng. 2017, 45, 148–163. [Google Scholar] [CrossRef]
- Yoon, S.-W.; Kim, S.-Y.; Jeon, J.-S.; Oh, S.; Chung, S.-Y.; Kim, J.-S.; Maeng, S.-K. 3D-printed Chlorella vulgaris biocarriers: A novel approach to wastewater treatment. J. Water Proc. Eng. 2024, 57, 104711. [Google Scholar] [CrossRef]
- Byrne, R.; Carrico, A.; Lettieri, M.; Rajan, A.K.; Forster, R.J.; Cumba, L.R. Bioinks and biofabrication techniques for biosensors development: A review. Mater. Today Bio 2024, 28, 101185. [Google Scholar] [CrossRef]
- Valich, L. Will your future clothes be made of algae? University of Rochester. Available online: https://www.rochester.edu/newscenter/will-your-future-clothes-be-made-of-algae-476562/ (accessed on 29 April 2021).
- Bito, T.; Okumura, E.; Fujishima, M.; Watanabe, F. Potential of Chlorella as a dietary supplement to promote human health. Nutrients 2020, 12, 2524. [Google Scholar] [CrossRef]
- Dimantides, N.; Wang, L.; Pruiksma, T.; Siemiatkoski, J.; Dugopolski, C.; Shortkroff, S.; Kennedy, S.; Bonassar, L.J. Correlating rheological properties and printability of collagen bioinks: The effects of riboflavin photocrosslinking and pH. Biofabrication 2017, 9, 034102. [Google Scholar] [CrossRef]
- Madison, I.; Tahir, M.; Van den Broeck, L.; Phan, L.; Horn, T.; Sozzani, R. Cell-material interactions in 3D bioprinted plant cells. bioRxiv 2024. [Google Scholar] [CrossRef]
- Ghosh, S.; Yi, H.-G. A Review on Bioinks and their Application in Plant Bioprinting. Int. J. Bioprint. 2022, 8, 612. [Google Scholar] [CrossRef]
- Krujatz, F.; Lode, A.; Brüggemeier, S.; Schütz, K.; Kramer, J.; Bley, T.; Gelinsky, M.; Weber, J. Green bioprinting: Viability and growth analysis of microalgae immobilized in 3D-plotted hydrogels versus suspension cultures. Eng. Life Sci. 2015, 15, 678–688. [Google Scholar] [CrossRef]
- North Carolina State University. “Bioprinting” Plant Cells With 3D Printer to Study Cell Function. SciTechDaily, 14 October 2022. Available online: https://scitechdaily.com/bioprinting-plant-cells-with-3d-printer-to-study-cell-function/ (accessed on 1 November 2024).
- Lode, A.; Krujatz, F.; Brüggemeier, S.; Quade, M.; Schütz, K.; Knaack, S.; Weber, J.; Bley, T.; Gelinsky, M. Green bioprinting: Fabrication of photosynthetic algae-laden hydrogel scaffolds for biotechnological and medical applications. Eng. Life Sci. 2015, 15, 177–183. [Google Scholar] [CrossRef]
- Alkhalf, M.I.; Khalifa, F.K. Blueberry extract attenuates γ-radiation-induced hepatocyte damage by modulating oxidative stress and suppressing NF-κB in male rats. Saudi J. Biol. Sci. 2018, 25, 1272–1277. [Google Scholar] [CrossRef]
- Groll, J.; Boland, T.; Blunk, T.; Burdick, J.A.; Cho, D.W.; Dalton, P.D.; Derby, B.; Forgacs, G.; Li, Q.; Mironov, V.A.; et al. Biofabrication: Reappraising the definition of an evolving field. Biofabrication 2016, 8, 013001. [Google Scholar] [CrossRef] [PubMed]
- Lee, J.M.; Sing, S.L.; Zhou, M.; Yeong, W.Y. 3D bioprinting processes: A perspective on classification and terminology. Int. J. Bioprint. 2018, 4, 151. [Google Scholar] [CrossRef]
- William, S.; Aarley, A.; Chung, L.B.C.; Toombs, J.B.; Cathal, D.; O’Connell, C.; Taylor, K.H.K.B.; Daniel, E.; Heath, A.; David, J.; et al. Advances in Biofabrication Techniques Towards Functional Bioprinted Heterogeneous Engineered Tissues: A Comprehensive Review, Bioprinting. 2021. Available online: http://creativecommons.org/licenses/by-nc-nd/4.0/ (accessed on 24 July 2024).
- Garreta, E.; Oria, R.; Tarantino, C.; Pla-Roca, M.; Prado, P.; Fernández-Avilés, F.; Campistol, J.M.; Samitier, J.; Montserrat, N. Tissue engineering by decellularization and 3D bioprinting. Mater. Today 2017, 20, 166–178. [Google Scholar] [CrossRef]
- Mironov, V.; Trusk, T.; Kasyanov, V.; Little, S.; Swaja, R.; Markwald, R. Biofabrication: A 21st century manufacturing paradigm. Biofabrication 2009, 1, 022001. [Google Scholar] [CrossRef]
- Vermeulen, N.; Haddow, G.; Seymour, T.; Faulkner-Jones, A.; Shu, W. 3D bioprint me: A socioethical view of bioprinting human organs and tissues. J. Med. Ethics 2017, 43, 618–624. [Google Scholar] [CrossRef]
- Gopinathan, J.; Noh, I. Recent trends in bioinks for 3D printing. Biomater. Res. 2018, 22, 11. [Google Scholar] [CrossRef]
- Kirillova, A.; Bushev, S.; Abubakirov, A.; Sukikh, G. Bioethical and Legal issues in 3D Bioprinting. Int. J. Bioprint. 2020, 6, 272. [Google Scholar] [CrossRef]
- Zhu, Y.; Joralmon, D.; Shan, W.; Chen, Y.; Rong, J.; Zhao, H.; Xiao, S.; Li, X. 3D printing biomimetic materials and structures for biomedical applications. Bio-Des. Manuf. 2021, 4, 405–428. [Google Scholar] [CrossRef]
- Tan, H.; Yang, K.; Wei, P.; Zhang, G.; Dimitriou, D.; Xu, L.; Huang, W.; Luo, X. A Novel Preoperative Planning Technique Using a Combination of CT Angiography and Three-Dimensional Printing for Complex Toe-to-Hand Reconstruction. J. Reconstr. Microsurg. 2015, 31, 369–377. [Google Scholar] [CrossRef]
- Handral, H.K.; Tay, S.H.; Chan, W.W.; Choudhury, D. 3D Printing of cultured meat products. Crit. Rev. Food Sci. Nutr. 2022, 62, 272–281. [Google Scholar] [CrossRef] [PubMed]
- Guo, X.; Wang, D.; He, B.; Hu, L.; Jiang, G. 3D Bioprinting of Cultured Meat: A Promising Avenue of Meat Production. Food Bioprocess Technol. 2024, 17, 1659–1680. [Google Scholar] [CrossRef]
- Ramirez, N. Assessing 3D Printability of Bioinks. Univ. Cent. Fla. Honor. Undergrad. Theses 2020, 748, 3–5. [Google Scholar]
- Ovsianikov, A.; Gruene, M.; Pflaum, M.; Koch, L.; Maiorana, F.; Wilhelmi, M.; Haverich, A.; Chichkov, B. Laser printing of cells into 3D Scaffolds. Biofabrication 2010, 2, 014104. [Google Scholar] [CrossRef]
- Hoque, M.E.; Chuan, Y.L.; Pashby, I. Extrusion based rapid prototyping technique: An advanced platform for tissue engineering scaffold fabrication. Biopolymers 2012, 97, 83–93. [Google Scholar] [CrossRef] [PubMed]
- Loukelis, K.; Helal, Z.A.; Mikos, A.G.; Chatzinikolaidou, M. Nanocomposite Bioprinting for Tissue Engineering Applications. Gels 2023, 9, 103. [Google Scholar] [CrossRef]
- Tønnesen, H.H.; Karlsen, J. Alginate in drug delivery systems. Drug Dev. Ind. Pharm. 2002, 28, 621–630. [Google Scholar] [CrossRef]
- Zeng, J.; Zeng, Z.; Cheng, Z.; Wang, Y.; Wang, X.; Wang, B.; Gao, W. Cellulose nanofibrils manufactured by various methods with application as paper strength additives. Sci. Rep. 2021, 11, 11918. [Google Scholar] [CrossRef] [PubMed]
- Zennifer, A.; Senthilvelan, P.; Sethuraman, S.; Sundaramurthi, D. Key advances of carboxymethyl cellulose in tissue engineering & 3D bioprinting applications. Carbohydr. Polym. 2021, 256, 117561. [Google Scholar] [PubMed]
- Ibar, J.P. The Challenges Facing the Current Paradigm Describing Viscoelastic Interactions in Polymer Melts. Polymers 2023, 15, 4309. [Google Scholar] [CrossRef] [PubMed]
- Jovic, T.H.; Kungwengwe, G.; Mills, A.C.; Whitaker, I.S. Plant-Derived Biomaterials: A Review of 3D Bioprinting and Biomedical Applications. Front. Mech. Eng. 2019, 5, 19. [Google Scholar] [CrossRef]
- Zhang, W.; Liu, Y.; Xuan, Y.; Zhang, S. Synthesis and Applications of Carboxymethyl Cellulose Hydrogels. Gels 2022, 8, 529. [Google Scholar] [CrossRef]
- Helmenstine, A.M. The Visible Spectrum: Wavelengths and Colors. ThoughCo., 7 June 2024. Available online: https://www.thoughtco.com/understand-the-visible-spectrum-608329 (accessed on 1 November 2024).
- “Plants in Action: A Resource for Teachers and Students of Plant Science”, Section 1.2.2, Australian Society of Plant Scientists. Available online: https://www.asps.org.au/publications/plants-in-action (accessed on 1 November 2024).
- Lichtenthaler, H.K.; Buschmann, C. Chlorophylls and Carotenoids: Measurement and Characterization by UV-VIS Spectroscopy. Curr. Protoc. Food Anal. Chem. 2001, 1, F4.3.1–F4.3.8. [Google Scholar] [CrossRef]
- Beer-Lambert Law, Edinburgh Instruments. Available online: https://www.edinst.com/us/blog/the-beer-lambert-law/ (accessed on 1 October 2023).
- Therriault, D.; White, S.R.; Lewis, J.A. Rheological Behavior of Fugitive Organic Inks for Direct-Write Assembly. Appl. Rheol. 2007, 17, 10112-1–10112-8. [Google Scholar] [CrossRef]
- Ribeiro, A.; Blokzijl, M.M.; Levato, R.; Visser, C.W.; Castilho, M.; Hennink, W.E.; Vermonden, T.; Malda, J. Assessing bioink shape fidelity to aid material development in 3D bioprinting. Biofabrication 2017, 10, 014102. [Google Scholar] [CrossRef]

| Step | Condition | Time | Speed (rpm) | Temperature (°C) | Outcome |
|---|---|---|---|---|---|
| Premixing NFC solution | 1% (w/v) NFC, under controlled conditions | 24 h | 750 | 23 | Reduced aggregation |
| Two-phase mixing | Hybrid hydrogel formulation with NFC, alginate, CMC | Phase 1: 24 h, Phase 2: 46 h | Phase 1: 750, Phase 2: 1150 | 23 | Superior homogeneity |
| Target Bioink | Hydrogel Composition (% w/v) | Temperature (°C) | Mixing Duration | Mixing Speeds (rpm) |
|---|---|---|---|---|
| S1-N1 | 1% NFC | 65 | 0.75 h + 0.67 h | 450 → 1000 |
| S1-C2 | 2% CMC | 90 | 0.5 h + 0.67 h | 750 |
| S1-A2:C1 | 2% Alginate, 1% CMC | 130 | 0.25 h + 0.5 h | 750 |
| S1-A2:N1 | 2% Alginate, 1% NFC | 95 | 0.5 h + 0.58 h | 750 |
| S1-A2 | 2% Alginate | 65 | 0.42 h + 1.5 h | 1000 |
| S1-A1 | 1% Alginate | 65 | 0.25 h + 1.42 h | 450 → 1000 |
| Target Bioink | Hydrogel Composition (% w/v) | Temperature (°C) | Mixing Duration | Mixing Speeds (rpm) |
|---|---|---|---|---|
| S2-A2 | 2% Alginate | 65 | 0.42 h + 1.5 h | 1000 |
| S2-N1 | 1% NFC | 65 | 0.75 h + 0.67 h | 450 → 1000 |
| S2-N1:A3 | 1% NFC, 3% Alginate | 80 | 0.67 h + 2 h + 11 h | 450 → 1000 |
| S2-N1:C0.5 | 1% NFC, 0.5% CMC | 90 | 0.67 h + 2 h + 17 h | 450 → 1000 |
| S2-N1:C0.25 | 1% NFC, 0.25% CMC | 90 | 0.67 h + 2 h + 17 h | 450 → 1000 |
| S2-A3:C0.5:N0.5 | 3% Alginate, 0.5% CMC, 0.5% NFC | 90 | 0.67 h + 2 h + 10 h | 450 → 1000 |
| S2-A3:C0.25:N0.5 | 3% Alginate, 0.25% CMC, 0.5% NFC | 90 | 0.67 h + 2 h + 10 h | 450 → 1000 |
| Bioink | Hydrogel Substrate Composition | Nomenclature for Substrate |
|---|---|---|
| S1-N1 | 1% NFC | N1 |
| S1-C2 | 2% CMC | C2 |
| S1-A2:C1 | 2% Alginate/1% CMC | A2:C1 |
| S1-A2:N1 | 2% Alginate/1% NFC | A2:N1 |
| S1-A2 | 2% Alginate | A2 |
| S1-A1 | 1% Alginate | A1 |
| S1-Media | In Media Only | Media |
| Bioink | Hydrogel Substrate Composition | Nomenclature for Substrate |
|---|---|---|
| S2-A2 | 2% Alginate | A2 |
| S2-Media | In Media Only | Media |
| S2-N1 | 1% NFC | N1 |
| S2-N1:C0.5 | 1% NFC/0.5% CMC | N1:C0.5 |
| S2-N1:C0.25 | 1% NFC/0.25% CMC | N1:C0.25 |
| S2-N1:A3 | 1% NFC/3% Alginate | N1:A3 |
| S2-A3:C0.5:N0.5 | 3% Alginate/0.5% CMC/0.5% NFC | A3:C0.5:N0.5 |
| S2-A3:C0.25:N0.5 | 3% Alginate/0.25% CMC/0.5% NFC | A3:C0.25:N0.5 |
| Bioink SE-N1 | Bioink SE-C2 | |
|---|---|---|
| Extrusion pressure (psi) | 15 | 15 |
| Mass of empty tube (g) | 6.491 | 6.544 |
| Mass of loaded bioink tube (g) | 17.275 | 17.841 |
| Net mass of bioink in tube (g) | 10.784 | 11.297 |
| Volume of bioink in tube (mL) | 11 | 11.5 |
| Density of bioink (g/mL) | 0.980364 | 0.982348 |
| Mass of empty petri dish (g) | 8.091 | 8.013 |
| Mass of petri dish with construct (g) | 9.559 | 8.213 |
| Net mass of construct (g) | 1.468 | 0.2 |
| Actual volume of construct (mL) | 1.497404 | 0.203594 |
| Theoretical volume of construct (mL) | 0.08 | 0.08 |
| Percentage difference in volume of construct (%) | 1871.754 | 254.4923 |
Disclaimer/Publisher’s Note: The statements, opinions and data contained in all publications are solely those of the individual author(s) and contributor(s) and not of MDPI and/or the editor(s). MDPI and/or the editor(s) disclaim responsibility for any injury to people or property resulting from any ideas, methods, instructions or products referred to in the content. |
© 2025 by the authors. Licensee MDPI, Basel, Switzerland. This article is an open access article distributed under the terms and conditions of the Creative Commons Attribution (CC BY) license (https://creativecommons.org/licenses/by/4.0/).
Share and Cite
Ayowole, O.; Lapp, J.; Khoda, B. Evaluation of Custom Microalgae-Based Bioink Formulations for Optimized Green Bioprinting. Materials 2025, 18, 753. https://doi.org/10.3390/ma18040753
Ayowole O, Lapp J, Khoda B. Evaluation of Custom Microalgae-Based Bioink Formulations for Optimized Green Bioprinting. Materials. 2025; 18(4):753. https://doi.org/10.3390/ma18040753
Chicago/Turabian StyleAyowole, Olubusuyi, Justin Lapp, and Bashir Khoda. 2025. "Evaluation of Custom Microalgae-Based Bioink Formulations for Optimized Green Bioprinting" Materials 18, no. 4: 753. https://doi.org/10.3390/ma18040753
APA StyleAyowole, O., Lapp, J., & Khoda, B. (2025). Evaluation of Custom Microalgae-Based Bioink Formulations for Optimized Green Bioprinting. Materials, 18(4), 753. https://doi.org/10.3390/ma18040753

